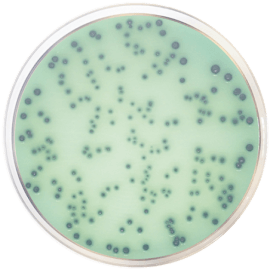
HEKTOEN ENTERIC AGAR 500 grams/bottle

Close
-
-
BRAIN HEART INFUSION AGAR (B.H.I. AGAR) 500 grams/bottle Brand: CONDALAB SKU: CDL/1048Ask for Price
-
-
-
-
Burkholderia cepacia Selective Agar Base USP 500 grams/bottle Brand: CONDALAB SKU: CDL/2201Ask for Price
-
-
-
-
-
-

Validate your login